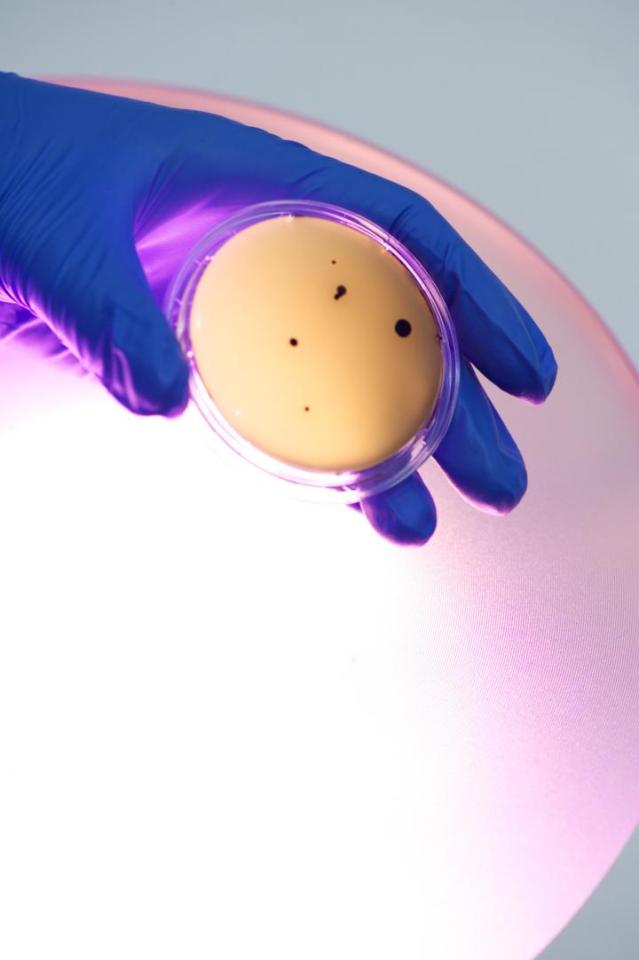
This is a microbial contamination on a contact agar plate with a 405nm light source in the background. Credit: University of Strathclyde

by University of Strathclyde
This is a microbial contamination on a contact agar plate with a 405nm light source in the background.
Credit: University of Strathclyde
Kenall Manufacturing today introduced Indigo-Clean™, a light fixture that uses Continuous Environmental Disinfection technology to continuously kill harmful bacteria linked to hospital acquired infections (HAIs). The technology behind Indigo-Clean™ inactivates a wide range of micro-organisms that are known causes of HAIs, including MRSA (Methicillin-resistantStaphylococcus aureus), C.difficile and VRE (Vancomycin-resistant Enterococcus).
Indigo-Clean™ is a light fixture manufactured through an exclusive licensing agreement with the University of Strathclyde in Glasgow, Scotland, which developed, proved and patented the technology. The light operates continuously and requires no operator, kills bacteria in the air and on all surfaces, and complies with all internationally recognized standards for patient safety. Indigo-Clean™ was unveiled just before the annual meeting of theAssociation for Professionals in Infection Control and Epidemiology (APIC) in Nashville.
“Indigo-Clean™ represents a breakthrough in helping to reduce HAIs,” said Jim Hawkins, CEO of Kenall. “It bolsters current disinfection efforts by infection preventionists and environmental services professionals in the fight against HAIs.”
Indigo-Clean™ uses a narrow spectrum of visible indigo-colored light at an output of 405 nanometers (nm) on the light spectrum. This High-Intensity Narrow Spectrum (HINS) light is absorbed by molecules within bacteria, producing a chemical reaction that kills the bacteria from the inside as if common household bleach had been released within the bacterial cells. Because the light is visible, it is lethal to pathogens but is safe for use in the presence of patients and staff.
“As part of Strathclyde’s clinical engagement in the U.K. over the last seven years, this technology has proven effective in killing bacteria in hospital settings. We are proud that the University of Strathclyde selected Kenall to commercialize this in the U.S.,” said Cliff Yahnke, Ph.D., Kenall’s Director of Clinical Affairs. “Breaking the chain of infection, from an infected patient, to the environment, to new patient, is vitally important, and the ability of this technology to be in use and effective at all times, will make a huge difference.”
Strathclyde’s technology has been in use since 2008 at Glasgow Royal Infirmary, a large teaching hospital operated by NHS (National Health Service) Greater Glasgow and Clyde. The technology and its effectiveness have been the subject of more than 20 peer-reviewed academic publications and 30 conference presentations since 2008. The HINS-light project was voted U.K. Research Project of the Year in 2011 by Times Higher Education magazine. Strathclyde gained a U.S. patent on the technology last year and recently granted Kenall licensing rights for the North American healthcare market.
The team at Strathclyde is based within the Robertson Trust Laboratory for Electronic Sterilisation Technologies (ROLEST) and includes Scott MacGregor, Ph.D., John Anderson, Ph.D. and Michelle Maclean, Ph.D.
“We have spent more than 13 years researching and developing HINS-light technology for the purpose of reducing the environmental transmission of pathogens and ultimately reducing HAI in the healthcare setting,” said MacGregor, ROLEST founder/co-director and Vice-Principal of Strathclyde. “Our partnership with Kenall in the United States is an exciting new chapter which will see this innovative technology become a commercially available product. We chose Kenall because of its extensive experience in providing lighting for the most challenging healthcare environments where infection prevention is a key consideration.”
The Centers for Disease Control and Prevention (CDC) reports around 1 in 25 hospital patients in the US have at least one infection contracted in the health care setting. The CDC estimates HAIs cause at least 1.7 million illnesses and 99,000 deaths in acute care hospitals in the U.S. and add $35-45 billion in excess health care costs each year. Battling an HAI can often add tens of thousands of dollars to the cost of treating a single patient. HAIs can also result in significant financial penalties for hospitals under the Affordable Care Act. For example, those providers scoring poorly in the Hospital-Acquired Condition (HAC) program receive lower Medicare reimbursements.
Yahnke added that while current methods of disinfecting the healthcare environment are effective, the methods are episodic and results are short-lived as bacteria immediately re-populate the space. The ability of Indigo-Clean™ to continuously treat the air as well as hard and soft surfaces, provides a significant boost to cleaning and disinfecting efforts. Unlike high-tech systems that clean only when they are activated by a trained operator, Indigo-Clean™ is automatic and continuous.
“As an innovator in healthcare lighting and a leader in LED lighting and controls, we can bring healthcare providers this effective, game-changing tool to ensure the safest and best environment for their patients,” said Hawkins.
Kenall, which completed a new state-of-the-art manufacturing facility just north of Chicago in late 2014, is poised to start commercial production of the technology immediately. The company also provides a clinical partners program to assist hospitals in evaluating the performance and cost savings potential of this technology. For additional information, visithttp://www.Indigo-Clean.com, see us on Facebook or Twitter or call (800) 4-KENALL.
Reprinted with permission of University of Strathclyde









